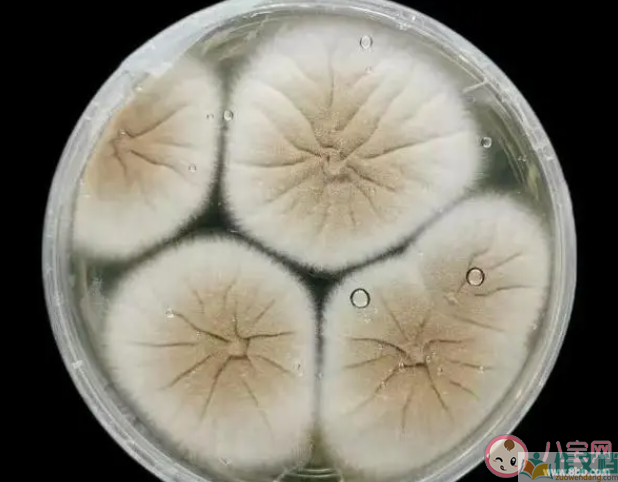

不要忽视霉菌对身体的危害 霉菌会对身体有哪些伤害
真的不要忽视霉菌对身体的危害,霉菌是一种无处不在的微生物,可以在家庭中常见的物品上生长,如食物、衣物、家具等。那么霉菌会对身体有哪些伤害?下面作文档小编带来介绍。

不要忽视霉菌对身体的危害
霉菌孢子在房间里会飘散在空气中,被人吸入肺部引发感染,轻则气短乏力,重则癌变。
家里墙体发霉的一定要注意除霉,可以先用刷子把发霉的地方刷干净,再用软布蘸着酒精轻轻擦拭,最后用稀释的漂白剂清洗被霉菌污染的墙体,清理完后记得开窗通风。
霉菌的生长和繁殖受到多种因素的影响,包括水分、温度、基质、通风等条件。
水分是霉菌生长繁殖的主要条件之一,保持一定的湿度水平对于防止霉菌生长至关重要。一般来说,相对湿度在70%以上、饲料或谷物中水份含量在17-18%时生长良好。
温度对霉菌的繁殖及产毒均有重要影响,不同种类的霉菌其最适温度是不一样的,大多数霉菌繁殖最适宜的温度为25~30℃,在0℃以下或30℃以上,不能产毒或产毒力减弱。

食品基质是霉菌生长繁殖的重要条件,不同的食品基质对霉菌的生长情况是不同的。一般来说,营养丰富的食品其霉菌生长的可能性就大,天然基质比人工培养基产毒为好。
通风条件也会影响霉菌的生长,通风不良的环境中容易滋生霉菌。
此外,霉菌的生长还与食品的种类、pH值、营养来源等因素有关。在食品生产和储存过程中,控制好水分、温度、基质、通风等条件,可以有效预防霉菌的生长和繁殖。
霉菌会对身体有哪些伤害
霉菌被世界卫生组织列为一等致癌物,其毒性是砒霜的68倍。霉菌的毒性可以通过消化系统、皮肤接触、呼吸道吸入等途径对人体健康造成影响,甚至增加癌症风险。
霉菌中的某些成分可以刺激胃酸和胃酸反流,引起不适。
霉菌中的一些成分可以引起哮喘和过敏反应,特别是在暴露在霉菌环境中时更容易发生。
霉菌可以刺激免疫系统,引起自身免疫性疾病,如类风湿性关节炎、系统性红斑狼疮等。
霉菌中的毒素和代谢产物可以影响肝脏和肾脏的解毒和排泄功能,导致肝炎、肾病等疾病。
霉菌还可能引起致畸风险,影响孕妇和胎儿的健康。
为了减少霉菌对身体的危害,应采取以下措施:保持室内通风,定期清洗和晾晒衣物、被褥等物品,保持厨房卫生和餐具清洁,避免食用发霉变质的食品等。如果发现家中存在霉菌滋生的情况,应及时采取措施进行清理和除湿,以减少对身体的危害。
总之,霉菌对身体的危害不容忽视。了解霉菌的危害和采取预防措施对于维护身体健康非常重要。
不要忽视霉菌对身体的危害 霉菌会对身体有哪些伤害相关文章:
